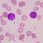

Reflecting on Errors and Missed Opportunities in CLL
Curriculum:
Reflecting on Errors and Missed Opportunities in CLL
Reflecting on Errors and Missed Opportunities in CLL
Credits:
1 AMA PRA Category 1 Credit(s) ™
1 AMA PRA Category 1 Credit(s) ™
Launch Date:
April 11, 2017
April 11, 2017
Expiration Date:
The accreditation for this activity has expired.
The accreditation for this activity has expired.
Primary Audience:
Oncology specialists, including physicians, nurse practitioners, and physician assistants
Relevant Terms:
Chronic lymphocytic leukemia
Ian W. Flinn, MD, PhD
Ian W. Flinn, MD, PhD
Director of Lymphoma/CLL Program
Sarah Cannon Center for Blood Cancer
Nashville, TN
Bio
 Ian W. Flinn, MD, PhD, is Director of the Blood Cancer Research Program at the Sarah Cannon Research Institute in Nashville, Tennessee. Dr Flinn also serves as Director for the Sarah Cannon Center for Blood Cancer at Tennessee Oncology and TriStar Centennial Medical Center.
Ian W. Flinn, MD, PhD, is Director of the Blood Cancer Research Program at the Sarah Cannon Research Institute in Nashville, Tennessee. Dr Flinn also serves as Director for the Sarah Cannon Center for Blood Cancer at Tennessee Oncology and TriStar Centennial Medical Center.Dr Flinn received his bachelor's degree in economics from Georgetown University in Washington, D.C. and graduated from Johns Hopkins University School of Medicine in Baltimore. He then completed his internship and residency at the University of Michigan Medical Center in Ann Arbor. He earned a fellowship in oncology and hematology, as well as a PhD in clinical investigations from Johns Hopkins University School of Medicine. Before joining the Sarah Cannon Research Institute, Dr Flinn was an Associate Professor of Oncology at Johns Hopkins, where he also served as Director of the Lymphoma Program and Assistant Director for Clinical Research at the Sidney Kimmel Comprehensive Cancer Center.
Dr Flinn's clinical practice is restricted to patients with hematologic malignancies, particularly those with lymphoma and chronic lymphocytic leukemia. His research is focused on the development of new therapies for patients with these disorders. These studies range from first in human to phase III trials.
Richard R. Furman, MD
Richard R. Furman, MD
The Morton Coleman, MD Distinguished Associate Professor of Medicine
Division of Hematology and Oncology
Weill Cornell Medical College
New York, NY
Bio
 Richard R. Furman, MD, is the Morton Coleman, MD Distinguished Associate Professor of Medicine in the Division of Hematology and Oncology at Weill Cornell Medical College in New York, New York. He received his medical degree from Mount Sinai School of Medicine, and completed a residency in internal medicine at the Hospital of the University of Pennsylvania in Philadelphia, as well as a fellowship in Hematology/ Oncology at Weill Cornell Medical College.
Richard R. Furman, MD, is the Morton Coleman, MD Distinguished Associate Professor of Medicine in the Division of Hematology and Oncology at Weill Cornell Medical College in New York, New York. He received his medical degree from Mount Sinai School of Medicine, and completed a residency in internal medicine at the Hospital of the University of Pennsylvania in Philadelphia, as well as a fellowship in Hematology/ Oncology at Weill Cornell Medical College.As a clinician-scientist, Dr Furman's research interest has been on developing non-chemotherapeutic treatments for patients with CLL and non-Hodgkin's lymphoma. He has played a key role in the development of ibrutinib, acalabrutinib, idelalisib, and venetoclax and continues his research on how to best utilize these agents.
William G. Wierda, MD, PhD
William G. Wierda, MD, PhD
Distinguished Professor, D.B. Lane Cancer Research
The University of Texas MD Anderson Cancer Center
Houston, TX
Bio
 William G. Wierda, MD, PhD, is Professor and Center Medical Director in the Department of Leukemia at The University of Texas MD Anderson Cancer Center. He received his MD/PhD degree from the University of Health Sciences/The Chicago Medical School, North Chicago, with an internship and residency at Duke University Medical Center in Durham, NC, and a Fellowship at University of California, San Diego, CA.
William G. Wierda, MD, PhD, is Professor and Center Medical Director in the Department of Leukemia at The University of Texas MD Anderson Cancer Center. He received his MD/PhD degree from the University of Health Sciences/The Chicago Medical School, North Chicago, with an internship and residency at Duke University Medical Center in Durham, NC, and a Fellowship at University of California, San Diego, CA.Dr Wierda's particular research interests in CLL are prognostic factors and developing prognostic models in CLL, immune and gene therapies for patients with CLL, developing chemoimmunotherapy regimens, and treatment strategies for relapsed and refractory patients with CLL. Dr Wierda is Head of the CLL Section in the Department of Leukemia where he is directing the clinical and translational efforts in CLL and low-grade lymphoproliferative diseases. In one of his many clinical trials, Dr Wierda was Principal Investigator on the pivotal trial of ofatumumab (Arzerra), a CD20 monoclonal antibody, for refractory patients with CLL. This trial led to FDA approval for ofatumumab. Dr Wierda is also the Director of the clinical core and clinical research of the CLL Research Consortium (CRC), a multicenter PO1 project headed by Dr Thomas Kipps at UCSD. In this role, Dr Wierda is directing and coordinating CLL-related clinical research activities at the participating sites, including Mayo Clinic, The Ohio State University, UCSD, Dana Farber Cancer Institute, Long Island Jewish Hospital, and MD Anderson Cancer Center. For the past several years, Dr Wierda has served on the NCCN Lymphoma Panel providing leadership and recommendations for CLL treatment within the NCCN guidelines. He has published many peer-reviewed articles on various clinical and translational aspects of CLL, and drug development, as well as given numerous lectures nationally and internationally.
| 1. | Implement advances in chronic lymphocytic leukemia (CLL) testing to help refine diagnosis, predict prognosis, and select the most appropriate personalized treatment approaches | 2. | Utilize new and emerging targeted treatments for CLL patients based on efficacy, clinical trial data, and guidelines in order to individualize treatment regimens |
| 3. | Integrate evidence-based strategies into the management of side effects associated with CLL treatments |
| 1. | Implement advances in chronic lymphocytic leukemia (CLL) testing to help refine diagnosis, predict prognosis, and select the most appropriate personalized treatment approaches |
| 2. | Utilize new and emerging targeted treatments for CLL patients based on efficacy, clinical trial data, and guidelines in order to individualize treatment regimens |
| 3. | Integrate evidence-based strategies into the management of side effects associated with CLL treatments |
PHYSICIAN CONTINUING MEDICAL EDUCATION
Accreditation Statement
This activity has been planned and implemented in accordance with the accreditation requirements and policies of the Accreditation Council for Continuing Medical Education (ACCME) through the joint providership of Albert Einstein College of Medicine and RMEI Medical Education, LLC. Albert Einstein College of Medicine is accredited by the ACCME to provide continuing medical education for physicians.
This activity has been planned and implemented in accordance with the accreditation requirements and policies of the Accreditation Council for Continuing Medical Education (ACCME) through the joint providership of Albert Einstein College of Medicine and RMEI Medical Education, LLC. Albert Einstein College of Medicine is accredited by the ACCME to provide continuing medical education for physicians.
Credit Designation
The Albert Einstein College of Medicine designates this enduring activity for a maximum of 1.0 AMA PRA Category 1 Credit(s)™. Physicians should claim only the credit commensurate with the extent of their participation in the activity.
Financial Disclosure
The “Conflict of Interest Disclosure Policy” of Albert Einstein College of Medicine requires that faculty participating in any CME activity disclose to the audience any relevant relationship(s) with a pharmaceutical, product, or device company. Any presenter whose disclosed relationships prove to create a conflict of interest with regard to their contribution to the activity will not be permitted to present.
Albert Einstein College of Medicine also requires that faculty participating in any CME activity disclose to the audience when discussing any unlabeled or investigational use of any commercial product or device not yet approved for use in the United States. Albert Einstein College of Medicine, CCME staff, has no relevant conflicts of interest with commercial interests related directly or indirectly to this educational activity.
The faculty reported the following financial relationships or relationships to products or devices they or their spouse/life partner have with commercial interests, but these relationships will not affect their ability to have an unbiased contribution to the educational content of this CME activity:
- Ian W. Flinn, MD, PhD, has affiliations with Acerta, BeiGene, Celgene, Genentech, Gilead, Infinity, Janssen, and TG Therapeutics (Contracted Research).
- Richard R. Furman, MD, has affiliations with AbbVie, Genentech, Gilead, Janssen, and Pharmacyclics (Consulting Fees); and Pharmacyclics (Speakers Bureau).
- William G. Wierda, MD, PhD, has affiliations with AbbVie, Celgene, Emergent, Genentech/Roche, Genzyme, Gilead, GlaxoSmithKline/Novartis, Merck, Pharmacyclics, and Sanofi (Consulting Fees); AbbVie, Ascerta, Emergent, Genentech, Gilead, GlaxoSmithKline/Novartis, Janssen, Juno, Karyopharm, Kite Pharma, and Pharmacyclics (Contracted Research).
RMEI Medical Education, LLC
- Jacqui Brooks, MBBCh, MRCPsych, has no affiliations with commercial interests to disclose.
- Chelsey Goins, PhD, has no affiliations with commercial interests to disclose.
- Sherri Kramer, MD, has no affiliations with commercial interests to disclose.
- Leslie Treff, JD, has no affiliations with commercial interests to disclose.
The following Einstein peer reviewer reported the following financial relationships or relationships to
products or devices they or their spouse/life partner have with commercial interests related to the
content of this CME activity:
- Amit K. Verma, MD, has no affiliations with commercial interests to disclose.
DISCLAIMER
Participants have an implied responsibility to use the newly acquired information to enhance patient outcomes and their own professional development. The information presented in this activity is not meant to serve as a guideline for patient management. Any procedures, medications, or other courses of diagnosis or treatment discussed or suggested in this activity should not be used by clinicians without evaluation of their patients' conditions and possible contraindications and/or dangers in use, review of any applicable manufacturer's product information, and comparison with recommendations of other authorities.
DISCLOSURE OF UNLABELED USE
This educational activity may contain discussion of published and/or investigational uses of agents that are not indicated by the FDA. The planners of this activity do not recommend the use of any agent outside of the labeled indications. The opinions expressed in the educational activity are those of the faculty and do not necessarily represent the views of the Albert Einstein College of Medicine, Montefiore Medical Center, RMEI Medical Education, LLC, or AbbVie. Please refer to the official prescribing information for each product for discussion of approved indications, contraindications, and warnings.
This educational activity may contain discussion of published and/or investigational uses of agents that are not indicated by the FDA. The planners of this activity do not recommend the use of any agent outside of the labeled indications. The opinions expressed in the educational activity are those of the faculty and do not necessarily represent the views of the Albert Einstein College of Medicine, Montefiore Medical Center, RMEI Medical Education, LLC, or AbbVie. Please refer to the official prescribing information for each product for discussion of approved indications, contraindications, and warnings.
Estimated time to complete: 1.0 hours
Medium: Internet
Medium: Internet
FEE INFORMATION
There is no fee for this educational activity.
COMMERCIAL SUPPORT
This activity is supported by an independent educational grant from AbbVie.
HOW TO RECEIVE CREDIT
By reviewing the course content and successfully completing the post-test and evaluation, physicians, nurse practitioners, and physician assistants are entitled to receive up to 1.0 AMA PRA Category 1 Credit(s)™. A statement of credit will be available to print from your user history page. Users must:
There is no fee for this educational activity.
COMMERCIAL SUPPORT
This activity is supported by an independent educational grant from AbbVie.
HOW TO RECEIVE CREDIT
By reviewing the course content and successfully completing the post-test and evaluation, physicians, nurse practitioners, and physician assistants are entitled to receive up to 1.0 AMA PRA Category 1 Credit(s)™. A statement of credit will be available to print from your user history page. Users must:
- Read the learning objectives and faculty disclosures.
- Participate in the activity.
- Complete the activity evaluation.
Physicians, nurse practitioners, and physician assistants who successfully complete the post-test and evaluation will receive CME credit. You must score 75% or higher on the post-test to receive credit for this activity. All other participants who successfully complete the post-test and evaluation will receive a certificate of participation.
COURSE VIEWING REQUIREMENTS
| Supported Browsers: Internet Explorer 9.0+ for Windows 2003, Vista, XP, Windows 7, Windows 8.1 and above Google Chrome 28.0+ for Windows, Mac OS, or Linux Mozilla Firefox 23.0+ for Windows, Mac OS, or Linux Safari 6.0+ for Mac OSX 10.7 and above | Supported Phones & Tablets: Android 4.0.3 and above iPhone/iPad with iOS 6.1 or above. |

